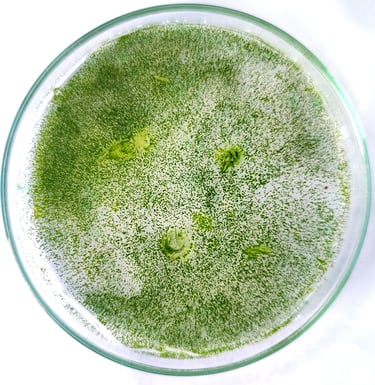

Build your future through advanced research
What our students say
Our lab offers internships, research projects, workshops, and outsourcing services- equipping you with advanced techniques and skills to excel in your career.




Join our community for research updates
Contact for Queries and Registration




Areas of Research

Drug discovery
Molecular biology
Cancer biology
Bioinformatics
Phycology

Internship
Projects
Courses Offered
Students till date
Research Area
Students till date

Sign-in for our newsletter, career, courses, updates and much more !
Newsletter
Get in touch
31, Kalapatty road,
Marvel parambariyam,
Saravanampatty,
Coimbatore - 641035
+91 90251 05158
தாமின் புறுவது உலகின் புறக்கண்டு
காமுறுவர் கற்றறிந் தார்.
-திருவள்ளுவர்
The learned foster more learning on seeing
the world enjoy their lore.
-Thiruvalluvar
1, Managaratchi complex,
Kamarajar Street, Near PS Park
Erode - 638001
genolitesrdl@gmail.com
+91 78710 54802














